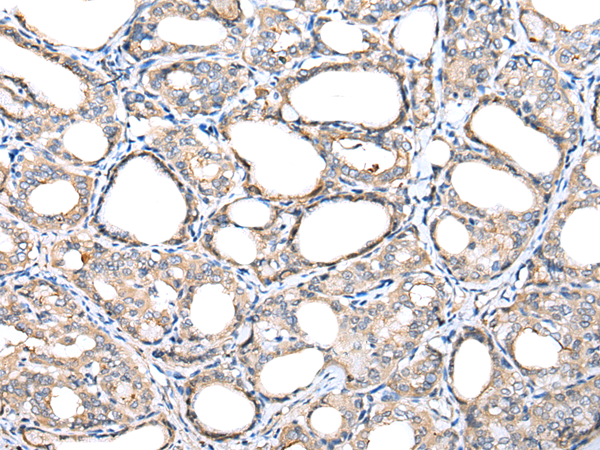

|
Background: |
Essential component of the TIM23 complex, a complex that mediates the translocation of transit peptide-containing proteins across the mitochondrial inner membrane. |
|
Applications: |
ELISA, WB, IHC |
|
Name of antibody: |
TIMM17A |
|
Immunogen: |
Full length fusion protein |
|
Full name: |
translocase of inner mitochondrial membrane 17A |
|
Synonyms: |
TIM17; TIM17A |
|
SwissProt: |
Q99595 |
|
ELISA Recommended dilution: |
5000-10000 |
|
IHC positive control: |
Human breast cancer and Human thyroid cancer |
|
IHC Recommend dilution: |
25-100 |
|
WB Predicted band size: |
18 kDa |
|
WB Positive control: |
RAW264.7,NIH/3T3,Hela and K-562 cell |
|
WB Recommended dilution: |
200-1000 |

購物車
幫助
021-54845833/15800441009
